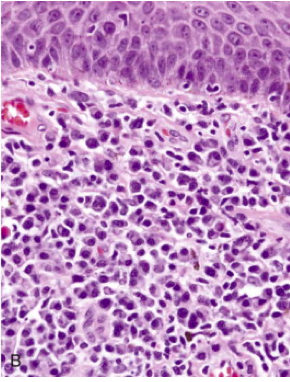

What causes Syphillis (aka lures)?
this is a chronic disease caused by the spirochete Treponema pallidum. AA are vastly more affected than whites
Can T. pallidum be transmitteda across the placenta from mother to fetus?
Yes, particularly during the arly stages of maternal infection
How does syphillis behave once in the body?
The organisms quickly disseminate to distant sites via lympatics anf blood, even before the appearance of lesions at the primary inoculation site
What are the symptoms of the primary stage of syphillis?
a painless, indurated chancre (aka hard chancre) (singular in males, multiple in women) appearing between 9-90 days (mean, 21 days) after infection at the point of spirochete entry. Systemic dissemination continues during this period, while the host immune system responds (this reponse does not fully clear the organism).
The chancre resolves spontaneously over a period of 4-6 weeks and is followed in approx 25% of untreated pts. by secondary syphillis

What are the symptoms of the secondary stage of syphillis?
Within approx 2 month of primary resolution, generalized LAD and mucocutaneous lesions (note that both the lesions of primary and secondary syphillis are packed with organisms and are HIGHLY infectious). These lesions commonly affect the palms of the hands and soles of the feet. In moist skin areas, such as the anogenital region, mouth, inner thighs, etc., elevated lesions termed condylomata lata may appear
These lesions also resolve spontaneously, allowing the pt. to enter what is called the early latent phase of syphillis
What are the symptoms of the tertiary stage of syphillis?
About 1/3 of pts will enter this phase (after about 5 yrs typically), marked by lesion development in the CV system, CNS (neuosyphillis), and gumma development. Pts. at this stage are much less infectious
NOTE: Syphillis and HIV both have a two-way permissive effect on each other (i.e. if you have HIV you are more likely to get syphillis, and vice-versa)
What are the most common CV manifestations of teritary syphillis?
syphilitic aortitis (80% of lesions)- more common in men
What causes gummas?
Gummas occur most commonly in bone, skin, and mucous membranes of the upper airway and mouth due to developing delayed hypersensitivity. (Spirochetes are rarely demonstartable within gummas).
NOTE: Penicillins have decreased the prevelance of gummas (they are now most common in AIDS pts.)
What is this?
proliferative endarteritis seen in syphillis around a chancre
What is this?

A positive Warthan-Starry stain for syphillis
What is this?

A Gumma marked by a central zone of coagulative necrosis surrounded by a mixed inflammatory infiltrate composed of lymphocytes, plasma cells, activated macrophages (epithelioid cells), occasional giant cells, and a peripheral zone of dense fibrous tissue.
T or F. The likelihood of transmission across the placenta is greatest during the early (primary and secondary) stages of syphillis, when spirochetes are most numerous.
T. Because the manifestations of maternal syphillis can be subtle, routine serologic testing for syphillis is mandatory for all pregnancies (in the absence of tx, as many as 40% of infected infants die in utero, typically after month 4 of gestation)
What are the manifestations congenital syphillis?
stillbirth (with signs of hepatomegaly, bone abnromalities, and peumonitis), and infantile syphillis
What are the symptoms of late, or tardive congenital syphilis (untreated congenital syphilis for 2+ yrs)?
Hutchinson triad: Notched central incisors (below), interstitial keratitis with blidness and deafness from CN XIII injury
-mulberry molars

What is saber shin deformity?
a potential manifestation of tardive congenital syphillis caused by chronic inflaammatio of the periosteum of the tibia

How is syphillis tested for?
serology is the mainstay (PCR does exist though), which include nontreponemal AB tests (measure Ab to cardiolipin that is detected via rapid plasma reagin) and anti-treponemal AB tests
Nontrepnemal Ab test are usually positive by 4-6 weeks of infection (however, they may revert to neagtive during the tertiary phase). Treponemal Ab tests also become + within 4-6 weeks but usually remain positive indefinitely, even after successful tx. NOTE: Serological response may be delayed or exaggerated in pts. with HIV
Notes about nontreponemal Ab tests:
1) Results are often negative during the early stages of disease, even in the presence of a primary chancre. Hence, during this period, direct visualizaiton of the spirochetes by darkfield may be the only way to confirm diagnosis
2) Up to 15% of VDRL test results can be due to APL syndrome